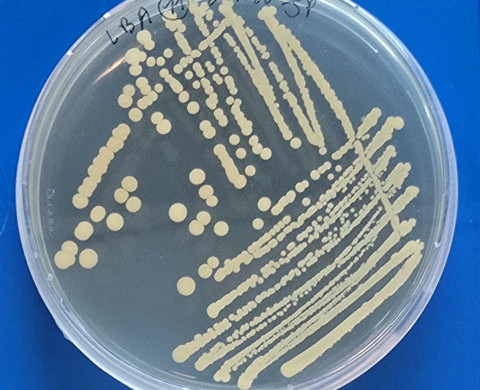
MiSeed

MiSeed
The MiSeed project is a 4-year project funded by the Dutch Research Council (NWO) that will be implemented in collaboration between The Netherlands Institute of Ecology (NIOO-KNAW) and Wageningen University & Research (WUR).
The overall aim of the project is to explore and exploit the unique and hidden potential of the seed microbiome.
Plants live in close association with diverse microorganisms to survive. These microbes can be vertically transmitted to the offspring via the seed. This project focuses on three main research questions which aim to: 1) determine whether plant genetics and seed characteristics affect the recruitment of microbes, 2) identify microbes that contribute to seed and plant performance under drought stress and 3) understand the mechanisms underlying these beneficial plant-microbe interactions. Overall, this project contributes to improving seed and plant performance in a changing environment.
Experts
-

-
Saskia Gerards
Research assistant , Microbial Ecology
-
Joséphine Pottier
PhD Candidate , Microbial Ecology
